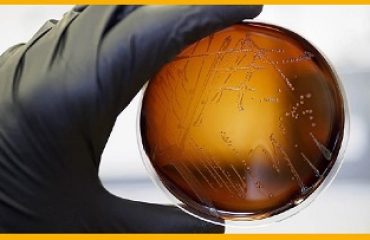

Asepeyo distingue a diez empresas en la IV Edicion de los Premios Asepeyo a las mejores practicas preventivas, celebrada hoy en el Palau de les Arts Reina Sofia de Valencia.
Estos galardones tienen como objetivo reconocer a aquellas empresas asociadas a la Mutua que hayan destacado por sus proyectos en materia de prevencion de riesgos laborales. En total se han presentado 104 trabajos, de los cuales el jurado ha decidido distinguir como ganadores a 10 de ellos, y a 30 como finalistas.
La Junta Directiva de la Mutua ha otorgado en la categoria de Mejor practica para el control del riesgo. el primer premio a Acciona Infraestructuras, el segundo ha sido para Faurecia Automotive Exterios Espana y el tercero a Tecno Ambiente. En la categoria Mejor practica de gestion de la prevencion., Astilleros Canarios ha contado con el primer premio, Universidad Miguel Hernandez con el segundo y Elecnor ha recibido el tercer galardon. Tambien se han entregado dos distinciones a la pequena empresa en la categoria Mejor practica preventiva.: un primer premio para Itesal y un segundo para Onubense de Instrumentacion y Electricidad.
En la categoria Mejor contribucion preventiva de la representacion institucional de trabajadores y empresarios, la Comision de Control y Seguimiento de Asepeyo ha decidido premiar ex aequo a las empresas Universidad Autonoma de Madrid y UTE Los Hornillos.
Presidida por Rafael Barbera, director de la Direccion General de Ordenacion de la Seguridad Social, y Jose M Juncadella, presidente de la Mutua, el acto ha contado tambien con la presencia de autoridades de la Administracion y de instituciones representativas de la Comunidad Valenciana.
Con la finalidad de difundir los proyectos ganadores y finalistas de estos Premios y de dar a conocer determinadas practicas eficaces de gestion y control del riesgo en el ambito laboral, la Mutua ha publicado una monografia que recoge un resumen de todos los trabajos distinguidos, que se puede consultar en la web corporativa.